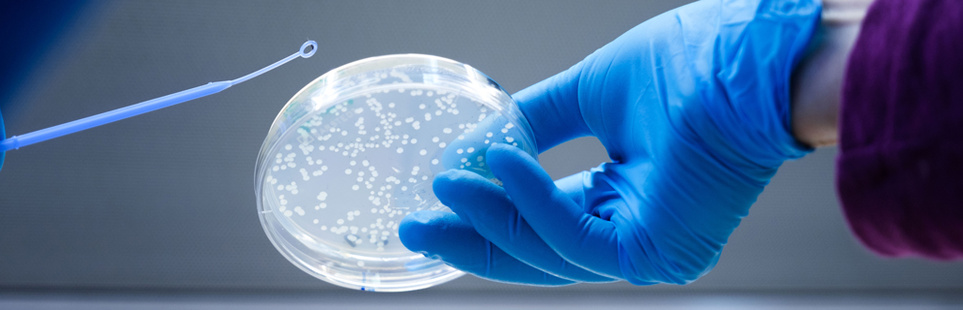
Eine Hand mit blauem Handschuh hält eine Petritschale, in der kleine Punkte zu sehen sind, von der anderen Seite wird eine Eine Impföse mit einem kleinen, kreisförmigen Spitze zur Petrischale geführt

Offene wöchentliche Sprechstunde für gründungsinteressierte Studierende

Forschung und Technologietransfer
Forschungsprofil
Forschung an der BHT zeichnet sich durch einen starken Anwendungsbezug aus. Hier erfahren Sie mehr über unsere Forschungsstrategie, -schwerpunkte, die internen Forschungsverbünde und über aktuelle Forschungsprojekte. mehr...
Forschungsförderung
Wir unterstützen Hochschulmitglieder, die Forschungsvorhaben umsetzen möchten: Wir beraten bei der Einwerbung von Drittmitteln, der Etablierung neuer Forschungskooperationen und bei Auftragsforschungsvorhaben. mehr...
Technologietransfer
Innovative Ideen sollen ihren Weg aus der Forschung in die Praxis und in die Lehre finden. Dafür bringen wir Unternehmen und Hochschulmitglieder zusammen. Das BHT Startup Hub unterstützt Gründer*innen auf ihrem Weg. mehr...
Wissenschaftlicher Nachwuchs
Erfahren Sie, woran Promovierende und PostDocs der BHT arbeiten. Wir sind zudem Ansprechpartner*innen für Promovierende und Betreuende zu allen praktischen Fragen rund um Promotionen an der BHT. mehr...
Kontakt
Referat Forschung:
forschung[at]bht-berlin.de
Ansprechpersonen
Referat Technologietransfer:
technologietransfer[at]bht-berlin.de
Ansprechpersonen
Referat Nachwuchsförderung und wissenschaftliche Zusammenarbeit (NWZ):
nwz[at]bht-berlin.de
Ansprechpersonen






